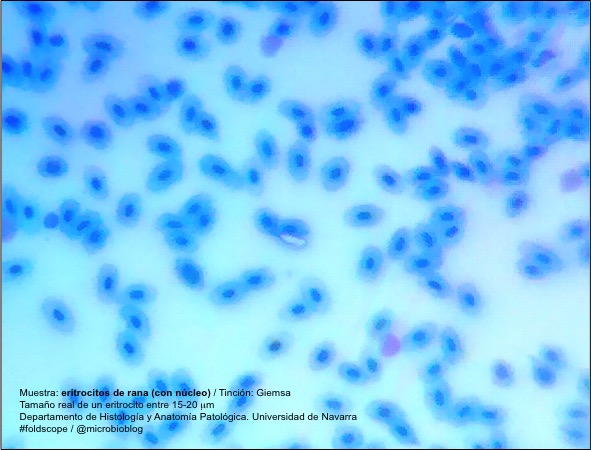
eritrocitos-rana.jpg

Activity

Microorganisms

Unknown

Fungi & Lichen

Plants

Insects

Animals

Non Living

Information

Workshops

Lesson Plans
Mediashowing 12 of 18

Photo posted on Dec 23, 2025
image

Photo posted on Dec 23, 2025
image

Photo posted on Dec 23, 2025
image

Photo posted on Dec 23, 2025
image
Photo posted on Dec 23, 2025
image

Photo posted on Dec 23, 2025
image

Photo posted on Dec 23, 2025
image

Photo posted on Dec 23, 2025
image

Photo posted on Dec 23, 2025
image

Photo posted on Dec 23, 2025
image

Photo posted on Dec 23, 2025
image

Photo posted on Dec 23, 2025
image
More Posts from Ignacio López-Goñishowing 3 of 3
Similar Foldscopers
No biography available.
No post images available.
Human observer of life. https://sukshmadarshin.wordpress.com
No post images available.
@Conacyt_MX research fellow at @LaUASLP 🇲🇽 studying the 🧠
with #fNIRS. 🏀 & 🎮 enthusiast. #SoyCátedraCONACYT
No post images available.
No biography available.
No post images available.
No biography available.
No post images available.
Hi! My name is Jaivats Agarwal, and I'm curious to learn. To deep dive into what is all around, yet untangible and invisible.
No post images available.
I am the Director Executivo de Conservación Panamá Inc.
I am an Ornithologist by training and a Conservation researcher.
The foldscope project we have is to bring science to the communities we work in!
We are an Estadounidenses/Panameña ONG focused on conservation research, proyectos, y educación ambiental.
www.conservacionpanamaca.org
ezekieljakub@conservacionpanamaca.org
No post images available.
No biography available.
No post images available.
No biography available.
No post images available.
Cody Geary is a Carlsberg Foundation Postdoctoral Fellow working at the Interdisciplinary Nanoscience Center at Aarhus University, advised by Ebbe Andersen. Cody works on developing RNA nanostructures that fold up from a single strand of RNA. The designs, dubbed 'RNA Origami', are being developed in collaboration with Paul Rothemund at Caltech and Ebbe Andersen at Aarhus University.
No post images available.

 Joined Jan 04, 2015
Joined Jan 04, 2015
 0 Applause
0 Applause 0 Comments
0 Comments









